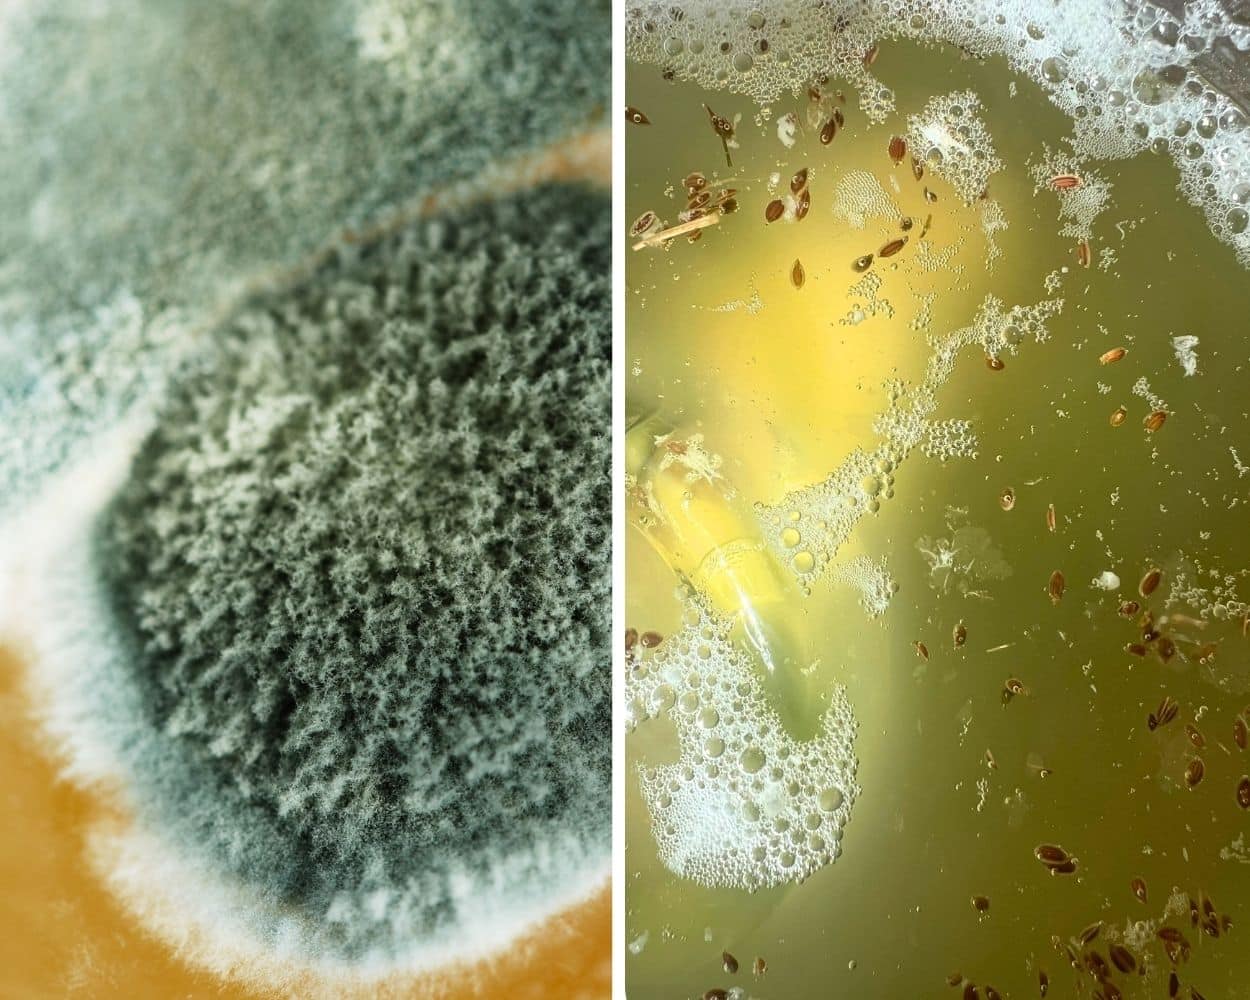
Schimmel im Vergleich zu Kahmhefe auf fermentierten Lebensmitteln mit sichtbaren Unterschieden in Struktur und Oberfläche

Gurken fermentieren: knackig und lecker. Salzgurken einfach selber machen (auch ohne Einlegegurken)
Mit 42 Jahren endete meine Kindheit.
Das klingt im ersten Moment befremdlich. Und du fragst dich vielleicht auch: Was hat das mit Gurken zu tun?
Wenn ich heute Gurken fermentiere, denke ich unweigerlich an meine Kindheit. Der Geruch von Dill und Knoblauch, der leicht säuerliche Geschmack und die knackige Haptik bringen mich zurück in eine Zeit, in der ich so klein war und die Welt so groß. Neben meinen Eltern begleitete mich meine Großmutter durch diese Zeit. Auf ihrem Küchentisch standen oft ganz selbstverständlich fermentierte oder sauer eingelegte Gurken und Tomaten.
Und so ist es kein Zufall, dass ich beim Schreiben dieses Beitrags wieder an sie denke, meine stolze schwarzmeerdeutsche Oma, geboren am Asowschen Meer, deportiert nach Sibirien und gestorben in Berlin. Sie hat mich bekocht, umsorgt und geprägt. Mein ganzes Leben lang war sie da. Eine Frau, die unerschrocken durchs Leben ging. Für mich fühlte es sich manchmal an, als sei sie unsterblich. Sie wurde einfach immer älter.
Im vergangenen Oktober starb sie im Alter von 101 Jahren, kurz bevor sie 102 geworden wäre. Und an diesem Tag wurde mir etwas klar. Es gibt auf dieser Welt niemanden mehr, dessen Enkelkind ich bin. In diesem Moment hatte ich das Gefühl, dass meine Kindheit mit ihr zu Ende gegangen ist, obwohl ich selbst längst Mutter bin. Vielleicht berührt mich dieser Beitrag deshalb so sehr. Vielleicht laufen mir deshalb beim Schreiben gerade Tränen über das Gesicht.
Fermentierte Gurken und Tomaten sind für viele Familien aus Osteuropa ein ganz selbstverständlicher Teil des Alltags. Für mich sind sie viel mehr als das. Sie sind ein kleines Stück Kindheit. Eine Erinnerung an meine geliebte Oma.
In diesem Artikel teile ich deshalb nicht nur zwei Rezepte.
Ich teile ein Stück meiner Familiengeschichte.
Gurken fermentieren klingt einfach. Aber wenn sie am Ende weich statt knackig sind, bringt dir das wenig. Genau deshalb zeige ich dir hier, wie du Gurken fermentieren kannst, sodass sie wirklich knackig bleiben.
Gurken fermentieren, so bleiben sie knackig
- funktioniert mit Einlegegurken und normalen Salatgurken
- dauert je nach Geschmack 2 bis 10 Tage
- benötigt nur Salz, Wasser und Gewürze
- Ergebnis: knackige, milchsauer fermentierte Salzgurken
Fermentierte Gurken lassen sich unkompliziert haltbar machen und gelingen auch Anfängern zuverlässig. Damit deine Gurken beim Fermentieren knackig bleiben, kannst du gezielt mit Gerbstoffen arbeiten.
Gurken fermentieren wie in Osteuropa
Lange bevor Essiggurken die Supermarktregale füllten, standen im Spätsommer in vielen Haushalten große Gefäße mit milchsauer vergorenen Gurken. In Osteuropa ist diese Tradition besonders verbreitet: In Polen heißen sie Ogórki kiszone, in Russland Soljonye ogurtsy und in der Ukraine Kwascheni ohirky. Auch in Rumänien (Castraveți murați), Ungarn (Kovászos uborka) oder in Tschechien und der Slowakei (Kvašené okurky) sind milchsauer vergorene Gurken ein fester Bestandteil der traditionellen Vorratshaltung.
Trotz unterschiedlicher Namen und kleiner Variationen basiert die Zubereitung fast überall auf demselben Prinzip: Salz, Wasser und Zeit.

Aus wenigen Zutaten entsteht etwas, das nach Kindheit schmeckt.
Warum Gurken beim Fermentieren sauer werden
Fermentierte Gurken schmecken anders als ihre in Essig eingelegten Verwandten. Bei der Milchsäuregärung wandeln natürliche Bakterien auf der Gurkenschale den im Gemüse enthaltenen Zucker in Milchsäure um. Dadurch entsteht ein saures Milieu, in dem sich unerwünschte Mikroorganismen kaum vermehren können.
Wenn du tiefer einsteigen willst: Fermentieren für Anfänger – Grundlagen, Sicherheit & erste Schritte einfach erklärt
Das Ergebnis: Die Gurken werden haltbar und entwickeln ihren typischen Geschmack, frisch, leicht säuerlich und würzig.
Gurken fermentieren ohne Einlegegurken. Funktioniert das?
Es ist keine Gurkensaison und du bekommst nur die großen Exemplare aus dem Supermarkt? Dann kannst du auch ganz normale Salatgurken verwenden.
Wenn du Gurken fermentieren willst, die knackig bleiben, kommt es auf ein paar entscheidende Dinge an:
- Kleine Snackgurken verwenden oder Gurken in Sticks schneiden und den weichen Kern entfernen
- 4 % Salzlake verwenden
- Meerrettich oder Kirschblätter hinzufügen
Schwarzer Tee für knackige fermentierte Gurken, der unterschätzte Trick
Wenn du keine klassischen gerbstoffhaltigen Zutaten wie Meerrettich, Weinblätter oder Kirschblätter zur Hand hast, gibt es eine einfache Alternative, die fast jeder zu Hause hat: schwarzer Tee.
Schwarzer Tee enthält von Natur aus Gerbstoffe, die die Struktur der Gurken stabilisieren können. Genau das ist entscheidend, wenn du vermeiden willst, dass deine fermentierten Gurken weich werden.
Anders gesagt: Gerbstoffe wirken wie ein kleines „Stützgerüst“ für die Zellstruktur deiner Gurken.
Das Ergebnis:
Die Gurken bleiben deutlich fester und knackiger, auch nach mehreren Tagen Fermentation.

Ein kleiner Trick mit großer Wirkung: Gerbstoffe aus schwarzem Tee helfen, die Gurken knackig zu halten

Schwarzer Tee enthält Gerbstoffe, die fermentierte Gurken knackig halten

Mit schwarzem Tee bleiben fermentierte Gurken deutlich fester
So verwendest du schwarzen Tee beim Fermentieren
Du kannst schwarzen Tee auf zwei Arten einsetzen:
- als abgekühlten Tee direkt in der Salzlake
- oder als Teebeutel bzw. lose Blätter mit ins Glas geben (Ich empfehle dir den Tee lieber im Beutel zu verwenden, damit die Teeblätter nicht am Ende an der Oberfläche schwimmen.)
Wichtig ist, dass der Tee nicht aromatisiert ist. Also kein Earl Grey oder Früchtetee, sondern ganz klassischer schwarzer Tee.
Ein kleiner Schluck oder ein Beutel reicht völlig aus.
Wann schwarzer Tee besonders sinnvoll ist
Schwarzer Tee ist ideal, wenn du keine Meerrettichwurzel oder Blätter zur Hand hast, du spontan fermentieren willst oder eine einfache, zuverlässige Lösung suchst.
Kurz gesagt: Kein Rettich im Haus? Nimm Tee. Funktioniert.

So sehen fermentierte Gurken aus, wenn du Gerbstoffe richtig nutzt
Rezept für klassisch fermentierte Salzgurken
Ganz klassisch fermentierst du Gurken mit Knoblauch, Dill, Pfeffer und etwas Meerrettich. Die Gurken liegen dabei für einige Tage in einer Salzlake und entwickeln so ihren typischen, frisch-säuerlichen Geschmack.
Je nach gewünschter Intensität fermentierst du sie etwa 2 bis 10 Tage. Danach stellst du sie kühl und kannst sie direkt genießen.
Das ausführliche Rezept für klassisch fermentierte Salzgurken findest du unten in der Rezeptbox.

Einlegegurken, Gewürze und ein bisschen Zeit – mehr brauchst du für echte Salzgurken nicht.

Die Gewürze geben den Ton an – von mild bis kräftig bestimmst du den Geschmack.

Gewürze im Säckchen verhindern, dass Senfkörner und Dill im Ferment herumschwimmen
Polnische vs russische Salzgurken. Wo liegt der Unterschied?
Polnische Salzgurken schmecken meist frisch, klar sauer und sind stark dillbetont. Sie werden häufig kürzer fermentiert und wirken dadurch leichter und sehr aromatisch.
Russische Varianten enthalten oft zusätzlich Johannisbeerblätter, Eichenblätter, Senfkörner oder Lorbeer. Dadurch werden sie im Geschmack etwas würziger, kräftiger und insgesamt komplexer. Die enthaltenen Gerbstoffe sorgen dabei vor allem für eine bessere Textur: Sie helfen, dass die Gurken beim Fermentieren knackig bleiben, ohne den Geschmack stark zu verändern.
Rezept für 24-Stunden-Salzgurken
Diese schnelle Variante fermentierter Gurken ist perfekt für den Einstieg. Die Gurken fermentieren nur kurz, bleiben besonders knackig und entwickeln einen milden, leicht säuerlichen Geschmack.
Schon nach etwa 12 Stunden schmecken sie frisch und nur leicht fermentiert. Nach 24 Stunden ist das Aroma deutlich ausgeprägter, nach 48 Stunden werden sie spürbar saurer.
Das ausführliche Rezept für 24-Stunden-Salzgurken findest du unten in der Rezeptbox.

Wenn du Gurken in Sticks schneidest und den weichen Kern entfernst, bleiben sie deutlich knackiger.

Jetzt kommt alles ins Glas, dicht geschichtet und bereit für die Lake

Von oben sieht man es gut: Alles liegt dicht beieinander und wartet auf die Fermentation.
Hol dir meine besten Einkoch-Tipps & Rezepte ins Postfach
Mache deine Vorratskammer smarter:
sichere Rezepte, Tipps & Tricks direkt
in dein Postfach!
Gurken fermentieren ohne Gärtopf. Diese Gefäße eignen sich
Du brauchst keinen speziellen Gärtopf, um Gurken zu fermentieren. In vielen Fällen hast du alles, was du brauchst, bereits zu Hause. Gut eignen sich zum Beispiel:
- Schraubgläser
- Bügelgläser
- klassische Einmachgläser
Wichtig ist vor allem, dass deine Gurken vollständig von der Salzlake bedeckt sind und möglichst wenig Sauerstoff an das Ferment gelangt.
Welche Gläser sich am besten eignen und worauf du achten solltest, zeige ich dir hier: Einmachgläser im Vergleich – welche Gläser sich zum Einkochen eignen
Kahmhefe oder Schimmel. Woran erkennt man den Unterschied?
Beim Fermentieren von Gurken kann sich auf der Oberfläche eine weiße Schicht bilden. Viele sind im ersten Moment unsicher: Ist das noch in Ordnung oder muss alles weg?
In vielen Fällen handelt es sich dabei um Kahmhefe. Du erkennst sie an einem dünnen, weißen Film mit matter Oberfläche. Kahmhefe ist meist geruchlos und nicht gefährlich, kann aber den Geschmack deiner fermentierten Gurken leicht beeinflussen.
Anders sieht es bei Schimmel aus. Schimmel ist oft flauschig, kann grüne, schwarze oder blaue Flecken bilden und riecht unangenehm. In diesem Fall solltest du dein Ferment nicht mehr verwenden.
Wenn du mehr über Kahmhefe wissen möchtest, lies meinen Beitrag „Warum entsteht Kahmhefe beim Fermentieren?“
Links siehst du Schimmel mit flauschiger, dichter Struktur. Rechts erkennst du Kahmhefe als dünnen, weißen Film auf der Oberfläche. Kahmhefe ist meist harmlos, Schimmel dagegen nicht.
Warum werden fermentierte Gurken weich und wie bleiben sie knackig?
Weiche Gurken gehören zu den häufigsten Problemen beim Fermentieren. Statt knackiger Salzgurken entsteht dann schnell eine eher weiche, manchmal sogar matschige Konsistenz. Viele denken, Gurken fermentieren sei idiotensicher. In der Praxis werden sie aber oft weich statt knackig.
Die häufigsten Ursachen sind:
- zu wenig Salz
- die falschen Gurken (z. B. sehr wasserreiche oder überreife Exemplare)
- Sauerstoffkontakt
- zu hohe Temperaturen während der Fermentation
Damit deine Gurken schön knackig bleiben, kannst du gezielt gegensteuern:
- die Salzmenge erhöhen, besonders bei Salatgurken
- den weichen, kernigen Teil entfernen und die Gurken in Sticks schneiden
- Meerrettich, Kirschblätter oder andere gerbstoffhaltige Zutaten hinzufügen
- alternativ etwas schwarzen Tee verwenden, denn auch er enthält Gerbstoffe
- darauf achten, dass die Gurken immer vollständig unter der Lake liegen
So schaffst du die besten Voraussetzungen für feste, aromatische und wirklich knackige fermentierte Gurken.
Wenn du zu Beginn noch ein Gemüse suchst, das nur schwer weich wird und meist seine Struktur behält, solltest du es damit probieren: „Karotten fermentieren. Einfaches Rezept für knackige fermentierte Karotten“.

So schichtest du die Gurken richtig: eng, aufrecht und komplett unter der Lake.
Die 5 häufigsten Fehler beim Gurken fermentieren
Damit deine fermentierten Gurken zuverlässig gelingen, lohnt es sich, die typischen Fehler zu kennen und zu vermeiden. Zu den häufigsten Fehlern gehören:
- zu wenig Salz in der Lake
- Gurken oder Gewürze, die nicht vollständig unter der Flüssigkeit liegen (Lösung für Gewürze: Teebeutel oder Gewürzei nutzen)
- zu warme Lagerung während der Fermentation
- alte oder überreife Gurken
- zu viel Sauerstoff im Gefäß
Wenn du diese Punkte im Blick behältst, hast du die wichtigsten Stellschrauben bereits im Griff.
Vermeidest du diese Fehler, gelingen deine Gurken nicht nur sicher, sondern werden auch richtig schön knackig und aromatisch.
Einen ausführlichen Beitrag zu allem was noch schief gehen kann, findest du in „Fermentationsfehler vermeiden: Die 6 häufigsten Probleme und wie du sie sofort löst“.
Meine Empfehlungen für dich (Affiliate-Links)
Für das Fermentieren brauchst du kein High-End-Equipment, aber ein paar Dinge erleichtern dir das Leben enorm:
- Fermentationsgewichte* (mit 8 cm Durchmesser passen sie prima in die Sturzgläser von Weck)
- Weck-Gläser *(850 ml)
- gutes unbehandeltes Salz*
- Baumwollsäckchen* oder Teeei* für Gewürze
*Affiliate-Links – beim Kauf unterstützt du meine Arbeit, ohne mehr zu bezahlen. Danke!*
Fazit: Gurken fermentieren lohnt sich. Und manchmal steckt mehr dahinter
Fermentierte Gurken kannst du zu Hause ganz einfach selbst zubereiten. Mit wenigen Zutaten entstehen aromatische Salzgurken, genau so, wie sie Menschen seit Jahrhunderten in vielen Küchen Europas machen. Ob klassische Fassgurken, schnelle 24-Stunden-Variante oder fermentierte Salatgurken: Das Prinzip ist immer gleich. Salz, Wasser und Zeit.
Und doch ist es manchmal mehr als nur ein Rezept. Wenn ich heute ein Glas öffne, rieche ich nicht nur Dill und Knoblauch. Ich rieche meine Kindheit. Ich sehe meine Großmutter vor mir, ihren Küchentisch und höre ihre Stimme.
Vielleicht ist das das Schönste am Fermentieren: Dass du nicht nur Lebensmittel haltbar machst, sondern auch Erinnerungen bewahrst. Und vielleicht bedeutet ein Glas Gurken für dich irgendwann auch mehr als nur ein Rezept.
FAQ – Häufige Fragen zum Fermentieren von Gurken
Wie viel Salz braucht man für fermentierte Gurken?
Für fermentierte Gurken brauchst du in der Regel eine Salzlake mit 2 bis 3 % Salz. Das entspricht etwa 20 bis 30 Gramm Salz pro Liter Wasser. Diese Konzentration reicht für klassische Einlegegurkenvöllig aus.
Wenn du normale Salatgurken verwendest, die mehr Wasser enthalten, kann eine stärkere Salzlake sinnvoll sein. In diesem Fall sind etwa 4 % empfehlenswert, damit die Gurken stabil bleiben und schön knackig werden. Wichtig ist, das Salz vollständig im Wasser aufzulösen, bevor du es über die Gurken gießt.
Wie lange müssen Gurken fermentieren?
Gurken fermentieren je nach Geschmack etwa 2 bis 10 Tage. Nach 2 bis 3 Tagen sind sie mild und leicht säuerlich. Nach 5 bis 7 Tagen entwickeln sie den typischen Geschmack klassischer Salzgurken. Lässt du sie länger stehen, werden sie deutlich kräftiger und saurer.
Du kannst die Gurken während der Fermentation probieren und selbst entscheiden, wann sie für dich perfekt sind. Danach stellst du sie am besten kühl. Das verlangsamt die Fermentation.
Kann man fermentierte Gurken im Kühlschrank lagern?
Ja, fermentierte Gurken lassen sich problemlos im Kühlschrank lagern. Die niedrigen Temperaturen verlangsamen die Aktivität der Milchsäurebakterien. Dadurch bleibt der Geschmack stabil und die Gurken säuern nicht weiter stark nach.
Achte darauf, dass die Gurken auch im Kühlschrank vollständig von der Lake bedeckt sind, damit sie geschützt bleiben.
Warum müssen Gurken vollständig unter der Lake bleiben?
Gurken müssen vollständig unter der Lake bleiben, damit kein Sauerstoff an sie gelangt. Die Milchsäuregärung funktioniert am besten unter sauerstoffarmen Bedingungen. Ragen Gurken aus der Flüssigkeit heraus, können sich dort leichter Schimmel oder unerwünschte Mikroorganismen bilden.
Ein Gewicht oder ein kleiner Deckel im Glas hilft dabei, dass alles unter der Lake bleibt.
Kann ich Gurken auch ohne spezielles Zubehör fermentieren?
Ja, du kannst Gurken problemlos ohne spezielles Zubehör fermentieren. Du brauchst keinen Gärtopf oder teure Ausrüstung. Schraubgläser, Bügelgläser oder klassische Einmachgläser reichen völlig aus.
Wichtig ist vor allem, dass das Gefäß sauber ist und die Gurken vollständig mit Salzlake bedeckt sind. Ein Gärtopf kann praktisch sein, ist aber keine Voraussetzung.
Warum werden meine fermentierten Gurken weich?
Fermentierte Gurken werden meist weich, wenn die Bedingungen nicht optimal sind. Häufige Ursachen sind zu wenig Salz, sehr wasserreiche oder überreife Gurken, zu hohe Temperaturen oder Sauerstoffkontakt.
Damit deine Gurken knackig bleiben, kannst du mit etwas mehr Salz arbeiten, besonders bei Salatgurken, den weichen Kern entfernen und gerbstoffhaltige Zutaten wie Meerrettich, Kirschblätter oder auch schwarzen Tee hinzufügen.
Ist Kahmhefe bei fermentierten Gurken gefährlich?
Kahmhefe ist in der Regel nicht gefährlich, kann aber den Geschmack beeinflussen.
Du erkennst sie an einem dünnen, weißen Film auf der Oberfläche. Sie ist meist geruchlos und lässt sich einfach abschöpfen.
Wichtig ist die Unterscheidung zu Schimmel. Schimmel ist flauschig, verfärbt sich und riecht unangenehm. In diesem Fall solltest du das Ferment nicht mehr verwenden.
Wie kann ich Gurken fermentieren, ohne dass sie weich werden?
Wenn du Gurken fermentieren willst, die knackig bleiben, solltest du auf frische Gurken, ausreichend Salz und Gerbstoffe achten.

Klassische fermentierte Salzgurken
Zutaten
- 600-800 g Einlegegurken oder Snackgurken
- 1 L Wasser
- 30 g Salz (ca. 3 %)
- 2-3 Knoblauchzehen
- 1-2 Dillstängel oder 1 TL Dillsamen
- 1 TL schwarze Pfefferkörner
- optional: 1 Stück Meerrettich, einige Kirsch- oder Johannisbeerblätter (alternativ: etwas schwarzer Tee, wenn du keine anderen gerbstoffhaltigen Zutaten zur Hand hast)
Anleitungen
- Salzlake anrühren: Löse das Salz vollständig im Wasser auf, bis sich keine Kristalle mehr zeigen.
- Gurken vorbereiten: Wasche die Gurken gründlich. Schneide bei Bedarf den Blütenansatz ab. Große Gurken halbierst du längs oder schneidest sie in Sticks und entfernst den weichen Kern.
- Gewürze einfüllen: Lege Knoblauch, Dill, Pfeffer und optional Meerrettich oder Blätter auf den Boden eines sauberen Glases (optional in einem Teebeutel / einem Teeei). Wenn du keine anderen gerbstoffhaltigen Zutaten da hast, kannst du stattdessen auch etwas schwarzen Tee dazugeben.
- Gurken schichten: Stelle die Gurken dicht an dicht in das Glas, damit sie möglichst wenig Spielraum haben.
- Lake aufgießen: Gieße die Salzlake über die Gurken, bis alles vollständig bedeckt ist.
- Beschweren: Drücke die Gurken mit einem Gewicht oder kleinen Glasdeckel unter die Lake, sodass nichts herausragt.
- Fermentieren lassen: Stelle das Glas bei Zimmertemperatur ab und lasse die Gurken 2 bis 10 Tage fermentieren.
- Reife prüfen und kühlen: Probiere zwischendurch. Sobald dir der Geschmack gefällt, stellst du das Glas in den Kühlschrank und verlangsamst so die Fermentation.
Notizen
- Verwende Meerrettich oder Kirschblätter, wenn du besonders knackige Gurken möchtest
- Alternativ kannst du auch schwarzen Tee verwenden, denn er enthält ebenfalls Gerbstoffe
- Arbeite bei Salatgurken besser mit 4 % Salz
- Bläschen und leichte Trübung zeigen dir, dass die Fermentation aktiv läuft

24-Stunden-Salzgurken (schnelle Variante)
Zutaten
- 1 kg Gurken (Snackgurken oder Salatgurken)
- 1 Liter Wasser
- 30 g Salz (ca. 3 %)
- 2–3 Knoblauchzehen
- 1–2 Dillstängel oder 1 TL Dillsamen
Anleitungen
- Salzlake anrühren: Löse das Salz vollständig im Wasser auf.
- Gurken vorbereiten: Wasche die Gurken gründlich. Schneide größere Gurken in Stücke oder Sticks.
- Gewürze einfüllen: Gib Knoblauch und Dill in ein sauberes Glas. (entweder lose oder in einem Teebeutel / Teeei)
- Gurken schichten: Fülle die Gurken dicht in das Glas.
- Lake aufgießen: Bedecke alle Gurken vollständig mit der Salzlake.
- Fermentation starten: Stelle das Glas bei Raumtemperatur ab.
- Zeitpunkt bestimmen: Nach 12 Stunden schmecken die Gurken mild und frisch. Nach 24 Stunden entwickeln sie ein deutlich intensiveres Aroma. Nach 48 Stunden gehen sie in eine klassische Fermentation über.
- Kühl lagern: Stelle die Gurken in den Kühlschrank, sobald sie für dich perfekt schmecken.
Notizen
- Perfekt für Einsteiger, die Fermentation ausprobieren möchten.
- Der Geschmack verändert sich schnell, probiere regelmäßig.
- Halte die Gurken immer vollständig unter der Lake.





















